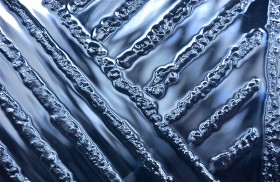

Play SlideshowFrom the Heights; Remarkables; Queenstown, South Island, New Zealand
-

-
The lift; Queenstown, South Island, New Zealand. January 2014.
-

-
Cast a giant shadow; Queenstown, South Island, New Zealand. January 2014.
-

-
At the top; Queenstown, South Island, New Zealand. January 2014.
-

-
Clearing; Queenstown, South Island, New Zealand. January 2014.
-

-
Tree tops, peaks; Queenstown, South Island, New Zealand. January 2014.
-

-
Where mountains touch the clouds; Queenstown, South Island, New Zealand. January 2014.
-

-
Peaks; Remarkables; Queenstown, South Island, New Zealand. January 2014.
-

-
Limbo; sky above, land below; Queenstown, South Island, New Zealand. January 2014.
-

-
Illusion; Queenstown, South Island, New Zealand. January 2014.
-

-
Bent; Queenstown, South Island, New Zealand. January 2014.
-

-
One after another; Queenstown, South Island, New Zealand. January 2014.
-

-
Coming, going; Queenstown, South Island, New Zealand. January 2014.
-
-
Three-way; Queenstown, South Island, New Zealand. January 2014.
-

-
Linearity; Queenstown, South Island, New Zealand. January 2014.
-

-
Abstract; Queenstown, South Island, New Zealand. January 2014.
-

-
Rolling on; Queenstown, South Island, New Zealand. January 2014.
-

-
Rough ridge; Queenstown, South Island, New Zealand. January 2014.
-

-
Clearing after a summer storm; Queenstown, South Island, New Zealand. January 2014.
-

-
Sliding into Lake Wakatipu; Queenstown, South Island, New Zealand. January 2014.
-

-
Mountain top lost; Remarkables, Lake Wakatipu; Queenstown, South Island, New Zealand. January 2014.
-

-
Remarkables detail; as clouds descend, mist prevails; Queenstown, South Island, New Zealand. January 2014.
-

-
Fron the heights; harbor, beyond; Queenstown, South Island, New Zealand. January 2014.
-

-
Cloud cover, Remarkables, Lake Wakatipu;sweeps toward the horizon; Queenstown, South Island, New Zealand. January 2014.
-

-
Folds of the Remarkables; Lake Wakatipu. January 2014.
-

-
The Remarkables; Lake Wakatipu; Queenstown, South Island, New Zealand. January 2014.
-

-
The Remarkables, Lake Wakatipu; Queenstown, South Island, New Zealand
This entry was posted in Abstracts, Architecture, Art, Business, Clouds, Featured, Galleries, Glass, Landscapes, Public / Governmental, Views and tagged Lake Wakatipu, New Zealand, Queenstown, Remarkables, South Island. Bookmark the
permalink. Both comments and trackbacks are currently closed.
From the Heights; Remarkables; Queenstown, South Island, New Zealand